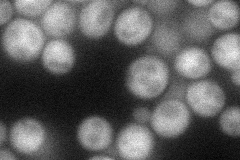
YPL077C

View description
Putative protein of unknown function; regulates PIS1 expression; mutant displays spore wall assembly defect in ether sensitivity screen; YPL077C is not an essential gene
Localization:
Intensity:
Fold change:
Significance:
-
C’ GFP library in SD

below threshold17.57 -
N' NOP1pr-GFP in SD
cytosol43.6774 -
N' TEF2pr-mCherry in SD

cytosol237.219 -
N' NATIVEpr-GFP in SD

below threshold20.859 -
N' TEF2pr-VC and Cyto-VN in SD

cytosol25.0087 -
C’ GFP library in SD+DTT

cytosol20.071.14No -
C’ GFP library in SD+H2O2

cytosol15.550.88No -
C’ GFP library in Starvation Media

cytosol21.711.23No -
C’ GFP library on the background of Pup2-DaMP

below threshold -
C’ GFP library on the background of CCT mutant

below threshold15.96320.907837No
